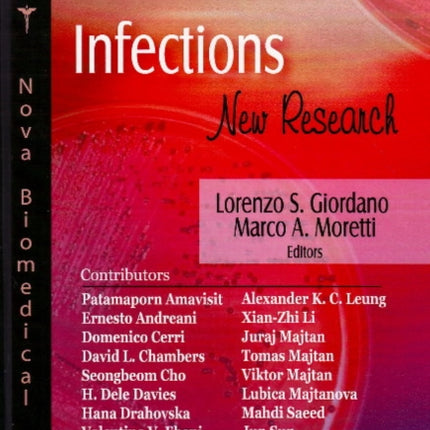
Salmonella Infections: New Research

Salmonella Infections: New Research
£89.99
Includes FREE deliveryRRP £119.99 – you save £30.00 (25%)
Order before 4pm today for delivery by Wed 17 Dec 2025.
A Hardback by Lorenzo S Giordano, Marco A Moretti
View other formats and editions of Salmonella Infections: New Research by Lorenzo S Giordano
Publisher: Nova Science Publishers Inc
Publication Date: 01/11/2008
ISBN13: 9781604567359, 978-1604567359
ISBN10: 160456735X
Also in:
Medical microbiology and virology
Medical microbiology and virology